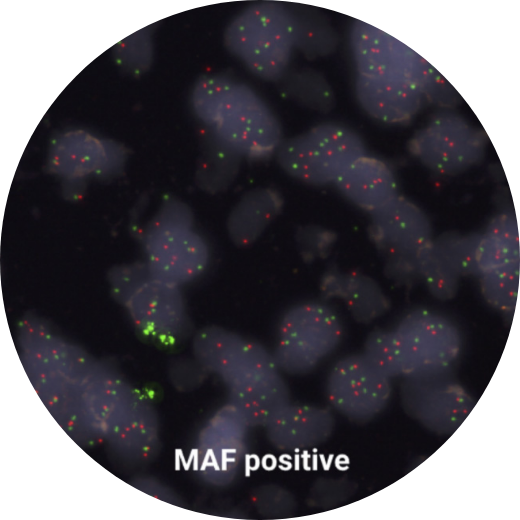
Mask Group 9

As a critical part of the chain, pathologists support oncologists in generating insights about their
patients that will define how they move forward.
By providing better insights with the MAF
Test®, pathologists support informed decisions to deliver personalised treatments.
As a multi-disciplinary team, this makes a true difference in the life of a patient.

MAF Test® employs high quality, reliable and easy-to-use DNA probes for fluorescence in situ hybridization (FISH) for the determination of MAF gene amplification in early breast cancer tumors.

The MAF (16q23) / D16Z3 FISH probe (MAF-Test®) is intended for use in a semi-qualitative fluorescence in situ hybridization assay to detect amplification involving the MAF gene region at 16q23 in a dual-color assay on formalin fixed paraffin embedded breast cancer tissue sections. The centromere 16 specific centromere repeat probe (D16Z3) is included as control on hybridization efficiency.
The MAF (16q23) gene region FISH probe is direct-labeled with PlatinumBright™550 (red). The D16Z3 control FISH probe is direct-labeled with PlatinumBright™495 (green).
for Pathologists

DISCOVER THE KNOWLEDGE THAT
WILL CHANGE YOUR PERSPECTIVE
Please leave your e-mail adress below - Receive the publications showing that the beneficial effects of bisphosphonates are associated with not having the amplified MAF gene in the primary breast tumor (MAF-negative);





































